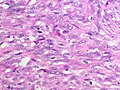

Metaplastic breast carcinoma
Jump to navigation
Jump to search
| Metaplastic breast carcinoma | |
|---|---|
| Diagnosis in short | |
 Metaplastic breast carcinoma. H&E stain. | |
|
| |
| LM | either (1) or (2): (1) malignant mesenchymal elements - either: (a) spindle cells or (b) osseous, chondroid or rhabdoid differentiation, (2) malignant squamous component - non-skin |
| LM DDx | fibromatosis, malignant phyllodes tumour, primary mammary sarcoma, mammary myofibroblastoma,nodular fasciitis. squamous cell carcinoma of the skin, malignant melanoma (desmoplastic) |
| IHC | S-100 -ve, AE1/AE3 +ve (epithelial elements only), CK7 +ve (epithelial elements only), p63 +ve (epithelial elements only), vimentin +ve, desmin -ve |
| Grossing notes | breast grossing |
| Staging | breast cancer staging |
| Site | breast - see invasive breast cancer |
|
| |
| Prevalence | uncommon |
| Prognosis | poor |
| Clin. DDx | other breast tumours |
Metaplastic breast carcinoma, also (less specifically) metaplastic carcinoma, is rare form of invasive breast cancer.
General
- May be difficult to diagnose.
- Prognosis - poor.
- Top of the differential diagnosis for spindle cell lesions of the breast.[citation needed]
Microscopic
Features - one of the following:[1][2]
- Malignant mesenchymal elements - either:
- Spindle cells.
- Osseous, chondroid or rhabdoid differentiation.
- Squamous component.
- Non-skin squamous cell carcinoma of the breast = metaplastic breast carcinoma.
Notes:
- Calcifications are uncommon.
- Cytology may be very bland, i.e. it may look very benign.
- May have minimal mitotic activity.
DDx:
- Fibromatosis.
- Malignant phyllodes tumour.
- Primary mammary sarcoma.
- Mammary myofibroblastoma.
- Nodular fasciitis.
- Squamous cell carcinoma of the skin.
- Malignant melanoma.
Images
- Metaplastic carcinoma (breastpathology.info).[1]
- Metaplastic carcinoma - case 1 - several images (upmc.edu).
- Metaplastic carcinoma - case 2 - several images (upmc.edu).
Subclassification
- There are various way to subclassify this subtype of breast cancer. This a consequence of physician automomy.
- There is a series of articles on the topic by Wargotz & Norris that is quite old... yet it is mentioned in Sterberg:[3]
- Matrix-producing carcinoma:[4]
- Features: cartilaginous and/or osseous stromal matrix; no osteoclastic giant cells.
- Spindle cell carcinoma:[5]
- Features: (non-malignant) spindle cells.
- Prognosis: better prognosis than other metaplastic carcinomas.
- Carcinosarcoma:[6]
- Features: malignant mesenchymal element.
- Prognosis: survival worse when compared to other metaplastic carcinomas.
- Squamous cell carcinoma of ductal origin:[7]
- Features: purely squamous; metastases are squamous cell carcinoma.
- Metaplastic carcinoma with osteoclastic giant cells:[8]
- Features: osteoclastic giant cells.
- The WHO subclassifies as follows:[9]
- Epithelial - includes: squamous cell carcinoma, adenocarcinoma with spindle cell differentiation, adenosquamous carcinoma.
- Mixed epithelial and mesenchymal - includes: carcinosarcoma, carcinoma with metaplasia (chondroid, osseous).
IHC
- S100 -ve (r/o melanoma).
- AE1/AE3 +ve (epithelial elements only).
- CK7 +ve (epithelial elements only).
- p63 +ve (epithelial elements only).
- Vimentin +ve.
- Desmin -ve.
- EMA -ve. (???)
- Almost invariably TRIPLE NEGATIVE for ER, PR and HER2
See also
References
- ↑ 1.0 1.1 URL: http://www.breastpathology.info/Case_of_the_month/2007/COTM_0807%20discussion.html. Accessed on: 28 November 2010.
- ↑ Barnes, PJ.; Boutilier, R.; Chiasson, D.; Rayson, D. (May 2005). "Metaplastic breast carcinoma: clinical-pathologic characteristics and HER2/neu expression.". Breast Cancer Res Treat 91 (2): 173-8. doi:10.1007/s10549-004-7260-y. PMID 15868445.
- ↑ Mills, Stacey E; Carter, Darryl; Greenson, Joel K; Reuter, Victor E; Stoler, Mark H (2009). Sternberg's Diagnostic Surgical Pathology (5th ed.). Lippincott Williams & Wilkins. pp. 328. ISBN 978-0781779425.
- ↑ Wargotz, ES.; Norris, HJ. (Jul 1989). "Metaplastic carcinomas of the breast. I. Matrix-producing carcinoma.". Hum Pathol 20 (7): 628-35. PMID 2544506.
- ↑ Wargotz, ES.; Deos, PH.; Norris, HJ. (Aug 1989). "Metaplastic carcinomas of the breast. II. Spindle cell carcinoma.". Hum Pathol 20 (8): 732-40. PMID 2473024.
- ↑ Wargotz, ES.; Norris, HJ. (Oct 1989). "Metaplastic carcinomas of the breast. III. Carcinosarcoma.". Cancer 64 (7): 1490-9. PMID 2776108.
- ↑ Wargotz, ES.; Norris, HJ. (Jan 1990). "Metaplastic carcinomas of the breast. IV. Squamous cell carcinoma of ductal origin.". Cancer 65 (2): 272-6. PMID 2153044.
- ↑ Wargotz, ES.; Norris, HJ. (Nov 1990). "Metaplastic carcinomas of the breast: V. Metaplastic carcinoma with osteoclastic giant cells.". Hum Pathol 21 (11): 1142-50. PMID 2227922.
- ↑ O'Malley, Frances P.; Pinder, Sarah E. (2006). Breast Pathology: A Volume in Foundations in Diagnostic Pathology series (1st ed.). Churchill Livingstone. pp. 214. ISBN 978-0443066801.